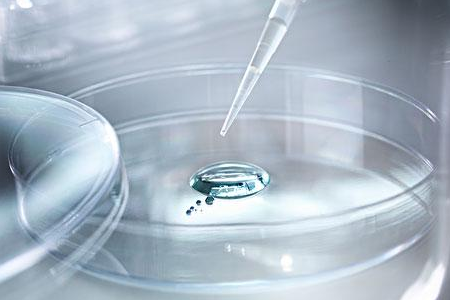
理科有哪些专业？

理学门类的专业有信息与计算科学、应用化学、物理学、化学、生物科学、生物技术、应用心理学、地理科学等等。
1、信息与计算科学是一门普通高等学校本科专业,属数学类专业,基本修业年限为四年,授予理学学士学位。
该专业是以信息技术、计算技术和运筹控制技术的数学基础为研究对象的理科类专业,培养具有良好的数学基础和数学思维能力,掌握信息或计算数学的基本理论、方法与技能,接受科学研究的初步训练,能解决信息技术或科学与工程计算中的实际问题的高级专门人才。

2、应用化学是一门培养具备化学方面的基础知识、基本理论、基本技能以及相关的工程技术知识和较强的实验技能,具有化学基础研究和应用基础研究方面的科学思维和科学实验训练,能在科研机构、高等学校及企事业单位等从事科学研究、教学工作及管理工作的高级专门人才的学科。

3、物理学主要研究物质运动规律和物质基本结构,是关于大自然规律的知识,探索分析大自然所发生的现象,以了解其形成原因及过程,例如:闪电、雨水的形成原因及过程,宇宙行星的运转规律、生活中电路短路断路的原因。

4、生物科学涉及领域相当广阔,包括植物学、动物学、微生物学、神经学、生理学、组织学、解剖学等等,主要研究生物的结构、生理行为和生物起源、进化与遗传发育等,例如:人体组织结构、人类基因遗传、细菌培养、基因工程等。
5、生物技术主要研习现代生物学和生物技术的基本理论、基本知识和基本技能,包括分子生物学、微生物学、基因工程、发酵工程及细胞工程等方面,主要利用生物体的物质来改进产品、改良植物和动物、或为特殊用途而培养微生物。常见的克隆、基因重组技术、生物疫苗培育皆隶属于此。

